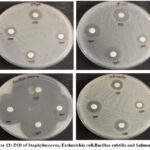
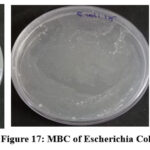
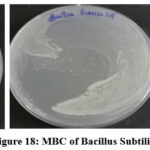
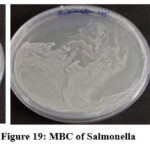
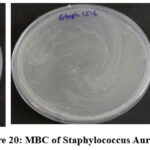
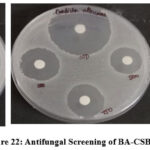

Bis –aldehyde Based Chitosan Schiff Base Polymer : Evaluation of Thermal, Cytotoxic, Antibacterial, Antioxidant, Anticancer and Wound Healing Properties
1Department of Chemistry, Presidency College, Chennai, India.
2Department of Chemistry, Institute of Chemical Technology, Tharamani, Chennai, India.
Corresponding Author E-mail:vjaisankar@gmail.com
DOI : http://dx.doi.org/10.13005/ojc/420126
ABSTRACT:Polymer composites based on natural polymer have received greater attention due to their biocompatible and biodegradable nature. Chitosan(CS) a natural polymer obtained from marine source extensively used for many biomedical applications. Chitosan is a bio-based polymer with comparable physico-chemical properties of cellulose. Hence, researchers have explored a number of chemical alterations in chitosan to enhance its characteristics and broaden its functional potential range. In this work, we report chitosan Schiff bases (CSB) were formed by interaction of CS with bis-aldehyde at room temperature and explore its biological properties. The synthesized compounds were characterized by various analytical techniques. Chitosan (CS) and its derivatives are garnering a lot of interest in a variety of settings. Higher solubility as compared to unmodified CS significantly improved biological studies such as antimicrobial activity against Klebsiella and Methicillin-resistant staphylococcus aureus (MRSA) and against yeasts (Candida albicans,Trichoderma viridae, and Aspergillus niger), paving the way for the potential use of these chemicals in the pharmaceutical industry as a means of preventing the spread of harmful microorganisms.
KEYWORDS:Anti-Microbial Activity; Bio Compatibility; Chitosan; Chitosan-Based Schiff Base; Natural Polymer
Introduction
Chitosan is a naturally occurring polycationic linear polysaccharide that is produced by partially deacetylating chitin. It is also called deacetylated chitin.1 Chitin is a fundamental part present in the exoskeleton of insects, shells (especially crabs, prawns and squid), and fungal cell walls. Chitosan is a second most abundant natural polysaccharide after the cellulose. Biodegradable and produced from plants, chitosan (CS) has remarkable film-forming properties. One other thing: it’s harmless, biodegradable, and compatible with living organisms. Aside from renewable materials found in nature, chitosan is also present in industrial processes.2 Chitosan has a primary amine on position C-2, a primary hydroxyl on position C-3, and a secondary hydroxyl on position C-6, in that order.3 The biological activity of chitosan is largely affected by the primary amine at C-2 of glutamine, one of three reactive groups responsible for this activity.4,5
Chitosan and its derivatives have significant use in several fields, including as biotechnology, cosmetics, the natural sciences, agriculture, the creation of functional foods, wastewater treatment, environmental protection, and the preservation of our planet.6 Antibiotic resistance research and the prevalence of bacteria, which may cause serious diseases, highlight the need to develop novel antibiotic compounds. The epidemiological and economic consequences of antibiotic resistance have made it the leading infectious disease concern at the present time.7 Furthermore, Everything from manufactured synthetic substances to establish removes, food handling side-effects to biofermentative cycles, and even municipal garbage might be considered as a potential therapeutic option to fight germs. All of these things have the makings of bioactive molecules that could have important effects, like antimicrobials or molecules that can dissolve biofilms or change how biofilms form. From this point of view, chitosan (CS) and other natural antimicrobial compounds are at the forefront of widespread interest in CS-related research around the world. Medicinal plants and natural substances have a long history of usage, and chitosan’s many useful qualities make it a promising candidate for further research into potential novel pharmacological and antibacterial uses. Interactions with various forms of chitosan (solutions, films, and composites) have been investigated in both in vivo and in vitro settings as a potential antibacterial agent against a variety of species, including yeasts, fungus, algae, and bacteria.8 Research on chitosan and its derivatives have been booming because to the material’s broad-spectrum antibacterial action, which was first suggested by Allan and Hardwiger.9 as well as its enormous economic potential. On considering the issues and findings in literature we account on the synthesis and characterization of bis-aldehyde based Schiff base Chitosan polymer and study its biological applications.
Experimental Methods
Materials
A Rgrade 4-fluorobenzaldehyde (98%), 4-hydroxybenzaldehyde (97%),anhydrousK2CO3. ethyl acetate, chloroform, and toluene purchased from Sigma Aldrich. Dimethyl sulfoxide and diethyl ether solvents from Merck. Also,the.Sigma Aldrich supplied the methanol, ethanol, and N, N-dimethylformamide.10
Methods
In a round bottom flak, 50 mL of 2 % was added slowly to 0.5 g of deacetylated chitosab with stirring. The above chitosan solution was agitated in a stirrer for three hours at 50 ◦C until a thick, yellow solution with a pH of 6.0 was formed.11,12 Then, 0.35 g of Bis-aldehyde dissolved in 15 mL of ethanol was added slowly , and the blend was disturbed continually with a reflux condenser for about 12 hours at 600C. White crystalline solids with a yield of 94% (0.72gm) are the end product of the reaction. The precipitate formed is filtered, washed with acetone, and then dried at 500C for six hours.
![]() |
Scheme 1: Chitosan and Bis-aldehyde Chitosan Schiff base. Click here to View Scheme |
Characterization Techniques
FT-IR spectrum for the compound obtained was studied using BURKER ALPHA-T ATR-FTIR spectrometer in between 4000 – 400cm-1. Surface morphology of samples was examined by scanning electron microscope (HR-SEM, S2600 HITACHI). The thermal properties were analyzed using Q500 HI-RES Thermogravimetric analyzer.
Results and Discussion
FTIR spectroscopy
For both chitosan and BA-CSB, the FTIR spectrum was observed from 4000-400cm-1 using a Perkin Elmer spectrometer. Absorption spectra for the BA-CSB sample, with the most important findings summarised inFigure 1. In the case of BA-CSB samples, it is important to note the absence of absorption in the area about 1651cm-1. It has been observed that the absorption profiles of -OH and -NH2 groups (specifically, OH and NH2 stretching vibrations) and C-O-C and C-N groups (particularly, asymmetric stretching of C-O-C and C-N) exhibit higher values compared to the imine bond (C=N stretching, imine), which is present with sufficient intensity in the spectral region around 1640 cm-1. It should be noted that there is complete spectral overlap at 1651 cm-1, where the C=O bond absorbs light (C=O tretching, amide 1). Therefore, no absorption in the area of 1651 cm-1 in the absorption ranges of samples BA-CSB. A comparison of the CS, BA-CSB absorption spectra with data presented by other groups11-16 shows agreement.
![]() |
Figure 1: IR Spectra for BA-CSB Click here to View Figure |
1H NMR spectroscopy
The proton NMR spectra of BA-CSB was recorded at a temperature of 298.5K, employing a BRUKER NMR Spectrometer with a frequency of 400 MHz and utilizing DMSO-d6 as the solvent. Figure 2 illustrates the 1H NMR spectrum derived from BA-CSB.Figure2 reveals the values of δ1.8 and 2.5-3.4 ppm due the presence of free hydrogen H2– H6 and -OCH3 attributed to chitosanare characteristic of chitosan.17 In particular, the chemical shift of the proton in aldehyde occurred at δ9.95 ppm in BA-CSB. Additionally, the hydrogen in imine of BA-CSB may be attributed to the new peak seen at 9.97 ppm and 9.92 ppm in chemical shift. The Chemical Shift δ7.1 and δ7.9 ppm indicates the Aromatic protons.
![]() |
Figure 2: C1H-NMR of Schiff Bis-Aldehyde-Chitosan Base(BA-CSB) Click here to View Figure |
13C NMR spectroscopy
13C NMR. spectra of the Bis- Aldehyde and BA-CSB are shown in Figure 3 and Table 1. In CS, the signals can be interpreted as δ=190.64 ppm, 160.99 ppm, 132.57 ppm, 119.57 ppm, 77.54 ppm and 76.69 ppm, this is in accordance with the previous reports. In BA-CSB, there are some new Carbon peaks: δ=39.05 – 40.72 ppm , δ=160.89pm, δ=192.24 ppm, δ=160.89 ppm, δ=132.89 ppm and δ=130.24 ppm.
![]() |
Figure 3: 13C-NMR spectrum of Bis-aldehyde and BA-CSB Click here to View Figure |
Table 1: 13C-NMR Spectral determination
| Compound | δ Value in ppm | Type of carbon |
| Bis Aldehyde | 190.64
119.37 |
Aldehydic carbon
Aromatic carbons |
| BA-CSB | 192.24
119.85 160.89 |
Aldehydic Carbons
Aromatic carbons Imine Carbon |
Thermal analysis.
Chitosan and its derivatives may have their thermal characteristics characterised with the use of DSC. At temperatures ranging from room temperature all the way up to 350°C, for the prepared sampl are shown in Figures4.1,4.2 & 4.3. Dehydration of water content may be associated with the large endothermic peak about 100 °C seen in the DSC spectra of chitosan. The peaks at 247°C and 250°C, respectively, are exothermic peak due to chitosan and Schiff base (I), which correlate to the thermal breakdown of the pyranose ring. The samples were subjected to thermogravimetric analysis inbetweenthe temperature range of 20 °C to 600 °C in order toinvestigate their stability after high temperature treatment.14-16
![]() |
Figure 4.1: TGA analysis of BA-CSBFigure Click here to View Figure |
![]() |
Figure 4.2: DTA of BA-CSB Click here to View Figure |
![]() |
Figure 4.3: DSC of BA-CSB Click here to View Figure |
Scanning Electron Microscopy
To find out how the samples looked on the surface, scanning electron microscopy was used. In addition, a cross-section was also taken to improve the material qualities of the films that were produced. The SEM pictures of Bisaldehyde-Chitosan (Fig.63–4) and all of the produced chitosan samples (Fig.51–2) are included in the Supplementary Materials. Chitosan powder has a spherical appearance with rounded corners. In subsequent processes, chitosan was modified into flat-structured structures. In line with the studies in the literature, all of these findings indicate that the chitosan was effectively manufactured.13
![]() |
Figure 5: 1 and 2: SEM Studies of Chitosan Click here to View Figure |
![]() |
Figure 6: 3 and 4-: SEM studies of Bisaldehyde- Chitosan Click here to View Figure |
Cytotoxicity Assay
To determine the viability of the synthesized materials for applications in the biomedical field, their cytotoxicity was assessed using the MTT assay. VERO cell lines obtained from and maintained by the National Centre for Cell Sciences (NCCS), Pune, India, were cultured in DMEM media, with 10% fetal bovine serum (FBS), penicillin (1000 U/mL), and streptomycin (100 ug/mL) in a humidified atmosphere of 5% CO₂ at 37 °C. The cells (1 × 10⁴/well) were plated into a 24-well plate, and once they reached ~80% confluence, they were treated with test articles at various concentrations for 24 hours. After 24 hours, the cells were washed with PBS or serum-free DMEM. Then 0.5% MTT solution (5 mg/mL) was added to the wells and then placed back into the incubator for another 4 hours. The formazan crystals formed were dissolved in DMSO (1 mL/well), and absorbance was read at 570 nm using a UV/vis spectrophotometer. Percent viability was calculated for each treatment and to determine the IC₅₀ values to characterize the cytotoxicity.
% Cell viability = A570 of treated cells / A570 of control cells × 100 – (1)
Graphs are plotted which was shown in the Figure 7. Each test includes a cell control and an example control to allow for a comprehensive comparison of cell viability evaluations (Figure 8).
Table 2: Study on the Sample’s Cytotoxicity Against the VERO Cell Line
| S.No. | Concentration (µg/ml) | Absorbance (O.D) | Cell Viability (%) |
| 1 | 1000 | 0.462 | 51.16 |
| 2 | 500 | 0.504 | 55.81 |
| 3 | 250 | 0.547 | 60.57 |
| 4 | 125 | 0.588 | 65.11 |
| 5 | 62.5 | 0.632 | 69.98 |
| 6 | 31.2 | 0.675 | 74.75 |
| 7 | 15.6 | 0.718 | 79.51 |
| 8 | 7.8 | 0.762 | 84.38 |
| 9 | Cell control | 0.903 | 100 |
![]() |
Figure 7: Cytotoxicity Assay Graphical representation of BA-CSB Click here to View Figure |
![]() |
Figure 8: Cytotoxicty Culture for BA-CSB Click here to View Figure |
Wound healing Assay
The wound healing assay is a commonly used in vitro assay for two-dimensional collective cell migration using VERO cell lines. The wound healing assay consists of applying controlled “wound” to a confluent monolayer of cells to assess how much they migrate into the wound. Cell migration is an important process for tissue repair and regeneration, as well as for cancer metastasis and development. VERO cells were seeded in six-well plates and allowed 24 hours for formation of a monolayer. After confirming the confluence of the cells in the well, a scratch was performed in the well with a sterile pipette tip, while treating the wells with a 100 µg/mL concentration of the sample or positive controls. All plates were then incubated further for 12 hours where cell migration into the wound was viewed using microscopy (Figure 3). The wound closure of 72% indicated that cell migration had occurred and demonstrated the properties of the material to induce wound healing. (Figure 9).
![]() |
Figure 9: a) Size of the wound 1.15 b) Size of the wound 0.32 Click here to View Figure |
![]()
Anti-cancer activity
MCF-7 breast cancer cells from NCCS, Pune, were cultured in DMEM with 10% FBS, penicillin (1000 U/mL), and streptomycin (100 µg/mL) in a humidified 5% CO₂ incubator at 37°C. For cytotoxicity assessment, cells (1 × 10⁴/well) were seeded in 24-well plates and treated with different concentrations of the test sample after reaching confluence. After 24 hours, wells were washed with PBS or serum-free DMEM, followed by the addition of MTT solution (0.5%, 5 mg/mL, 100 µL/well) and incubation for 4 hours. DMSO (1 mL) was added to dissolve formazan crystals, and absorbance was measured at 570 nm. Cell viability and IC₅₀ values were calculated to determine the cytotoxic effect.
% Cell viability = A570 of treated cells / A570 of control cells × 100 – (3)
Each test includes a cell control and a sample control to allow for a comprehensive comparison of cell viability evaluations(Figure 10 and Figure 11).
![]() |
Figure 10: Cell viability % of BA-CSB Click here to View Figure |
![]() |
Figure 11: MCF 7 cells Click here to View Figure |
Antibacterial Activity
Stock cultures were maintained on nutrient agar slants at 4°C. For testing, a loopful of culture was transferred into nutrient broth and incubated at 37°C for 24 hours to activate the culture. Antibacterial activity was assessed using the agar disc diffusion method on Mueller Hinton Agar (MHA). After the medium solidified in Petri dishes, bacterial inoculum was evenly spread using a sterile swab. Sterile discs loaded with 20 µL of the sample at concentrations of 1000 µg, 750 µg, and 500 µg were placed on the MHA plates and incubated at 37°C for 24 hours. The antibacterial effect was determined by measuring the diameter of the inhibition zones. Results are shown in Table 3 and Figure 12 t0 14.
Table 3: Zone of Inhibition
| S.NO. | Organisms | Zone of Inhibition (mm) | |||
| Sample (µg/ml) | Standard | ||||
| 1000 | 750 | 500 | |||
| 1. | Klebsiella | 19 | 12 | 10 | 29 |
| 2. | (MRSA) Methicillin- resistant staphylococcus aureus | 10 | 8 | 8 | 14 |
| 3. | Staphylococcus | 11 | 10 | 10 | 16 |
| 4. | Escherichia coli | 17 | 17 | 9 | 18 |
| 5. | Bacillus subtilis | 40 | 35 | 31 | 47 |
| 6. | Salmonella | 14 | 14 | 10 | 15 |
![]() |
Figure 12: ZOI of Klebiella and MRS Click here to View Figure |
![]() |
Figure 13: ZOI of Staphylococcus, Escherichia coli,Bacillus subtilis and Salmonella Click here to View Figure |
![]() |
Figure 14: ZOI vs concentration for BA-CSB Click here to View Figure |
Minimum Inhibitory Concentration
Bacterial inoculums were prepared by suspending 18–24-hour-old colonies in broth and adjusting turbidity to match the 0.5 McFarland standard (~1–2 × 10⁸ CFU/mL) using a white background with black lines for comparison. The suspension was then diluted to achieve a final concentration of ~5 × 10⁵ CFU/mL for testing.MIC was determined using the serial dilution method. Sterile LB broth (1 mL) was added to eight tubes and autoclaved. After cooling, 1 mL of the test sample was added to the first tube and serially diluted across the remaining tubes. Each tube received 100 µL of the prepared bacterial inoculum (including Salmonella, S. aureus, B. subtilis, and E. coli) and was incubated at 37°C for 24 hours. Turbidity was observed post-incubation, with the lowest concentration showing no visible growth recorded as the MIC. Results are depicted in Figures 15 and 16.
![]() |
Figure 15: (a)Salmonella(b) Escherichia Coli Click here to View Figure |
![]() |
Figure 16: (c )Staphylococcus Aureus(d) Bacillus Subtilis. Click here to View Figure |
Minimum Bactericidal concentration (MBC) determination
To determine the MBC, the Sample were drawn from(1000µg/ml,125µg/ml,15.6µg/ml) Tubes and plated enumerate the viable colonies by pour plate method. It was then incubated for 24 hours, the outcomes for this period were shown(Figure 17 to 20)(Table 4).
![]() |
Figure 17: MBC of Escherichia Col i Click here to View Figure |
![]() |
Figure 18: MBC of Bacillus Subtilis Click here to View Figure |
![]() |
Figure 19: MBC of Salmonella Click here to View Figure |
![]() |
Figure 20: MBC of Staphylococcus Aureus Click here to View Figure |
Table 4: MBC Determination
| ORGANISM | CONCENTRATION | OD VALUE |
| Escherichia Coli
Total Number of Colonies: 15 X 10-1, 33 X 10-4 and 112 X 10-7 |
1000 | 0.058 |
| 500 | 0.079 | |
| 250 | 0.106 | |
| 125 | 0.142 | |
| 62.5 | 0.211 | |
| 31.2 | 0.256 | |
| 15.6 | 0.321 | |
| Bacillus Subtilis
Total Number of Colonies: 14 X 10-1 , 48 X 10-4 and 96 X 10-7
|
1000 | 0.113 |
| 500 | 0.167 | |
| 250 | 0.219 | |
| 125 | 0.276 | |
| 62.5 | 0.354 | |
| 31.2 | 0.412 | |
| 15.6 | 0.498 | |
| Salmonella
Total Number of colonies: 32 X 10-1 and 54 X 10-4 Too Numerous to Count X10-7
|
1000 | 0.073 |
| 500 | 0.116 | |
| 250 | 0.185 | |
| 125 | 0.267 | |
| 62.5 | 0.308 | |
| 31.2 | 0.387 | |
| 15.6 | 0.453 | |
| Staphylococcus Aureus
Total Number of Colonies: 12 X 10-1, 46 X 10-4 Too Numerous to Count X10-7
|
1000 | 0.127 |
| 500 | 0.168 | |
| 250 | 0.249 | |
| 125 | 0.283 | |
| 62.5 | 0.376 | |
| 31.2 | 0.425 | |
| 15.6 | 0.498 |
Antifungal evaluation
The antifungal activity of Chitosan bis Schiff base (BA-CSB) was assessed using the agar well and disc diffusion methods against Candida albicans, Trichoderma viride, and Aspergillus niger. Fungal cultures were maintained on Sabouraud Dextrose Agar (SDA) slants at 4°C and activated by culturing in Sabouraud Dextrose Broth at room temperature for 48 hours. For the well diffusion assay, 1 mL of BA-CSB and its complexes was added to wells in SDA plates inoculated with fungal suspensions. In the disc diffusion assay, sterile SDA plates were swabbed with fungal inoculum, and sterile discs loaded with 20 µL of the sample or amphotericin B (positive control) were placed on the surface. Plates were incubated at 28°C for 24 hours [18]. Antifungal efficacy was determined by measuring the diameter of the zones of inhibition (ZOI), as shown in Figure 22.(Table 5 &Figure 21).
Table 5: Antifungal study – Zone of Inhibition(mm).
| Organism | Zone of inhibition (mm) | Standard | ||
| Sample(µg/ml) | ||||
| 1000 | 750 | 500 | ||
| Candida albicans | 23 | 21 | 20 | 40 |
| Trichoderma viride | 19 | 12 | 10 | 38 |
| Aspergillus niger | 27 | 17 | 17 | 40 |
![]() |
Figure 21: ZOI VS concentration for BA-CSB Click here to View Figure |
![]() |
Figure 22: Antifungal Screening of BA-CSB Click here to View Figure |
Antioxidant Assay
Antioxidants play a key role in neutralizing free radicals and preventing oxidative damage to cells and biomolecules[17-18]. Due to their effectiveness and affordability, synthetic antioxidants are gaining more attention over natural ones. In this study, the antioxidant potential of various Schiff bases and their metal complexes was evaluated using the DPPH assay.19 The DPPH (1,1-diphenyl-2-picrylhydrazyl) assay is based on the ability of antioxidant compounds to donate hydrogen atoms to stabilize the DPPH free radical, which is deep violet in color and shows a strong absorbance at around 520 nm. Upon reduction by an antioxidant (AH), DPPH loses its violet color, forming a light yellow reduced form.20 The decrease in absorbance is measured spectrophotometrically to assess radical scavenging activity.

![]() |
Figure 23: BHT -Standard and DPPH% Click here to View Figure |
Table 6: Anti-oxidant DPPH
| S.No. | Concentration (µg/ml) | O.D Value | Average | DPPH % | ||
| 1 | 200 | 0.582 | 0.585 | 0.580 | 0.582 | 10.87 |
| 2 | 400 | 0.524 | 0.526 | 0.522 | 0.524 | 19.75 |
| 3 | 600 | 0.461 | 0.463 | 0.459 | 0.461 | 29.40 |
| 4 | 800 | 0.378 | 0.380 | 0.376 | 0.378 | 42.11 |
| 5 | 1000 | 0.291 | 0.293 | 0.289 | 0.291 | 55.43 |
Conclusion
In conclusion, bis-aldehyde based chitosan Schiff base was successfully synthesized by simple one step rapid reaction. The functional characteristics of the synthsised polymer was confirmed by FTIR spectroscopy, thermal analysis and scanning electron microscopy (SEM). Additionally, the results of the cellular toxicity test indicated that Schiff base is non toxic. The studies revealed that the prepared bis-aldehydebased chitosan Schiff base are anti-oxidants, anti-cancer agent, and antibacterial agents. Also, it is observed that chitosanderivatives may preferentially enter cancer cells and exhibit pathways that work against cancer. The evidence of inhibitory zones against Klebsiella, MRSA (Methicillin-resistant staphylococcus aureus), E. coli shows the potential antibacterial characteristics. Hence, the results confirmed that the synthesized bis-aldehyde based chitosan Schiff base polymer is a potential biomaterial for medical applications.
Acknowledgement
The author sincerely thank Dr. I Seethalakshmi, Head Lifeteck research Centre for availing support towards bio-medical evaluation.
Funding Sources
The author(s) received no financial support for the research, authorship, and/or publication of this article.
Conflict of Interest
The author(s) do not have any conflict of interest.
Data Availability Statement
This statement does not apply to this article.
Ethics Statement
This research did not involve human participants, animal subjects, or any material that requires ethical approval.
References
- Chandy, T.; Sharma, C. P. Chitosan-as a biomaterial. Biomaterials Artificial Cells and Artificial Organs,1990, 18 (1), 1–2 https://doi.org/10.3109/10731199009117286.
CrossRef - Picos-Corrales, L. A.; Morales-Burgos, A. M.; Ruelas-Leyva, J. P.; Crini, G.; García-Armenta, E.; Jimenez-Lam, S. A.; Ayón-Reyna, L. E.; Rocha-Alonzo, F.; Calderón-Zamora, L.; Osuna-Martínez, U.; Calderón-Castro, A.; De-Paz-Arroyo, G.; Inzunza-Camacho, L. N. Chitosan as an outstanding polysaccharide improving Health-Commodities of Humans and environmental Protection. Polymers,2023, 15 (3), 526. https://doi.org/10.3390/polym15030526.
CrossRef - Packialakshmi, P.; Gobinath, P.; Ali, D.; Alarifi, S.; Gurusamy, R.; Idhayadhulla, A.; Surendrakumar, R. New Chitosan Polymer Scaffold Schiff bases as potential cytotoxic activity: synthesis, molecular docking, and physiochemical characterization. Frontiers in Chemistry,2022, 9. https://doi.org/10.3389/fchem.2021.796599.
CrossRef - Aranaz, I.; Harris, R.; Heras, A. Chitosan Amphiphilic Derivatives. Chemistry and Applications. Current Organic Chemistry,2010, 14 (3), 308–330. https://doi.org/10.2174/138527210790231919.
CrossRef - Pérez-Córdoba, L. J.; Norton, I. T.; Batchelor, H. K.; Gkatzionis, K.; Spyropoulos, F.; Sobral, P. J. A. Physico-chemical, antimicrobial and antioxidant properties of gelatin-chitosan based films loaded with nanoemulsions encapsulating active compounds. Food Hydrocolloids, 2017, 79, 544–559. https://doi.org/10.1016/j.foodhyd.2017.12.012.
CrossRef - Morin-Crini, N.; Lichtfouse, E.; Torri, G.; Crini, G. Fundamentals and applications of Chitosan. In Sustainable agriculture reviews; 2019; 49–123, https://doi.org/10.1007/978-3-030-16538-3_2.
CrossRef - La Fauci, V.; Costa, G. B.; Genovese, C.; Palamara, M. A. R.; Alessi, V.; Squeri, R. Drug-resistant bacteria on hands of healthcare workers and in the patient area: an environmental survey in Southern Italy’s hospital. https://pmc.ncbi.nlm.nih.gov/articles/PMC6719646/.
- Kong, M.; Chen, X. G.; Xing, K.; Park, H. J. Antimicrobial properties of chitosan and mode of action: A state of the art review. International Journal of Food Microbiology,2010, 144 (1), 51–63, https://doi.org/10.1016/j.ijfoodmicro.2010.09.012.
CrossRef - Allan, C. R.; Hadwiger, L. A. The fungicidal effect of chitosan on fungi of varying cell wall composition. Experimental Mycology,1979, 3 (3), 285–287. https://doi.org/10.1016/s0147-5975(79)80054-7.
CrossRef - Hafeez, A.; Akhter, Z.; Gallagher, J. F.; Khan, N. A.; Gul, A.; Shah, F. U. Synthesis, crystal structures, and spectroscopic characterization of bis-aldehyde monomers and their electrically conductive pristine polyazomethines. Polymers,2019, 11 (9), 1498. https://doi.org/10.3390/polym11091498.
CrossRef - Ali, M. A.; Musthafa, S. A.; Munuswamy-Ramanujam, G.; Jaisankar, V. 3-Formylindole-based chitosan Schiff base polymer: Antioxidant and in vitro cytotoxicity studies on THP-1 cells. Carbohydrate Polymers,2022, 290, 119501. https://doi.org/10.1016/j.carbpol.2022.119501.
CrossRef - Ali, M. A.; Aswathy, K. A.; Munuswamy-Ramanujam, G.; Jaisankar, V. Pyridine and isoxazole substituted 3-formylindole-based chitosan Schiff base polymer: Antimicrobial, antioxidant and in vitro cytotoxicity studies on THP-1 cells. International Journal of Biological Macromolecules,2022, 225, 1575–1587. https://doi.org/10.1016/j.ijbiomac.2022.11.214.
CrossRef - Liu, X.; Dan, N.; Dan, W.; Gong, J. Feasibility study of the natural derived chitosan dialdehyde for chemical modification of collagen. International Journal of Biological Macromolecules,2015, 82, 989–997. https://doi.org/10.1016/j.ijbiomac.2015.11.015.
CrossRef - Sionkowska, A.; Kaczmarek, B.; Michalska, M.; Lewandowska, K.; Grabska, S. Preparation and characterization of collagen/chitosan/hyaluronic acid thin films for application in hair care cosmetics. Pure and Applied Chemistry,2017, 89 (12), 1829–1839. https://doi.org/10.1515/pac-2017-0314.
CrossRef - Lewandowska, K.; Furtos, G. Study of apatite layer formation on SBF-treated chitosan composite thin films. Polymer Testing,2018, 71, 173–181. https://doi.org/10.1016/j.polymertesting.2018.09.007.
CrossRef - Lewandowska, K. Effect of an ionic liquid on the physicochemical properties of chitosan/poly(vinyl alcohol) mixtures. International Journal of Biological Macromolecules,2019, 147, 1156–1163,https://doi.org/10.1016/j.ijbiomac.2019.10.084.
CrossRef - Rahman, Md. M.; Islam, Md. B.; Biswas, M.; Alam, A. H. M. K. In vitro antioxidant and free radical scavenging activity of different parts of Tabebuia pallida growing in Bangladesh. BMC Research Notes,2015, 8 (1). https://doi.org/10.1186/s13104-015-1618-6.
CrossRef - Kurutas, E. B. The importance of antioxidants which play the role in cellular response against oxidative/nitrosative stress: current state. Nutrition Journal,2015, 15 (1). https://doi.org/10.1186/s12937-016-0186-5.
CrossRef - Engwa, G. A. Free radicals and the role of plant phytochemicals as antioxidants against oxidative Stress-Related diseases. In InTech eBooks; 2018, https://doi.org/10.5772/intechopen.76719.
CrossRef - Socea, L. I.; Visan, D. C.; Barbuceanu, S. F.; Apostol, T. V.; Bratu, O. G.; Socea, B. The Antioxidant Activity of Some Acylhydrazones with Dibenzo[a,d][7]annulene Moiety. Revista De Chimie,2018, 69 (4), 795–797. https://doi.org/10.37358/rc.18.4.6202.
CrossRef - Taghvaei, M.; Jafari, S. M. Application and stability of natural antioxidants in edible oils in order to substitute synthetic additives. Journal of Food Science and Technology,2013, 52 (3), 1272–1282. https://doi.org/10.1007/s13197-013-1080-1.
CrossRef
Accepted on: 13 Sep 2025
Second Review by: Dr. Subhrajit Ray
Final Approval by: Dr. Tanay Pramanik